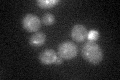
YPL053C
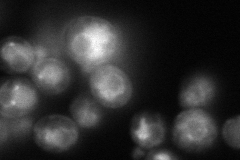
YPL053C

View description
Probable mannosylphosphate transferase involved in the synthesis of core oligosaccharides in protein glycosylation pathway; member of the KRE2/MNT1 mannosyltransferase family
Localization:
Intensity:
Fold change:
Significance:
-
C’ GFP library in SD
punctate24.48 -
N' NOP1pr-GFP in SD
ER,vacuole126.62 -
N' TEF2pr-mCherry in SD

ER,vacuole182.269 -
N' NATIVEpr-GFP in SD

ER,vacuole35.055 -
N' TEF2pr-VC and Cyto-VN in SD

#N/A0 -
C’ GFP library in SD+DTT

punctate17.180.7Yes -
C’ GFP library in SD+H2O2

punctate18.870.77Yes -
C’ GFP library in Starvation Media

punctate17.780.72Yes -
C’ GFP library on the background of Pup2-DaMP

punctate -
C’ GFP library on the background of CCT mutant

punctate19.75570.806801No
